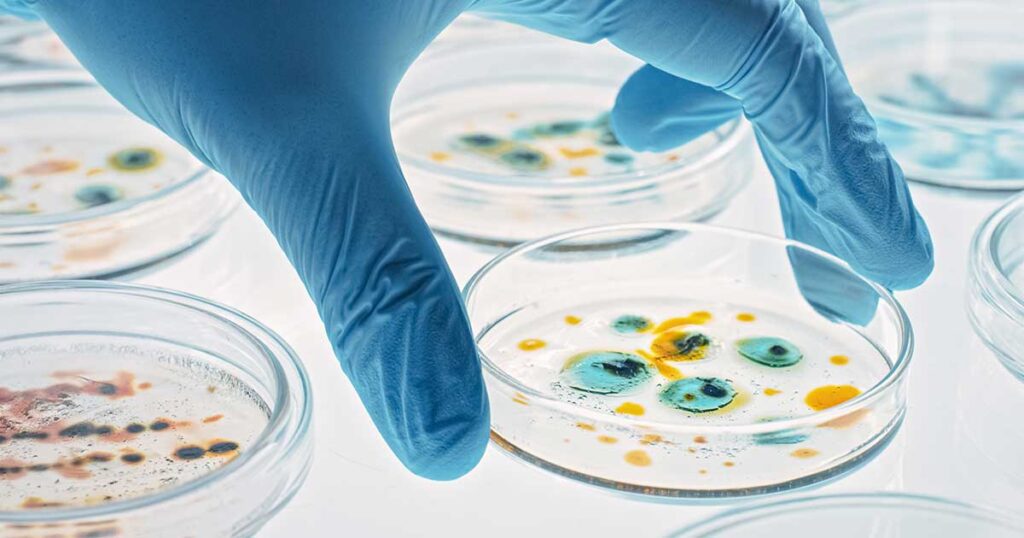

医薬品製造施設/研究施設
Pharmaceutical factories/research facilities
サービス一覧
Service List
施設のメンテナンス

空調エアフィルター交換
クリーンルームの清浄環境を維持するための心臓部

環境検査(塵埃・温湿度・風速・風量・差圧・残留抗がん剤測定)
手術室など清浄環境が保持されているかの検査を行います

清浄区域クリーンアップ
ISO17025準拠バリデーションに対応

ホルムアルデヒドガス燻蒸殺菌
ISO17025準拠バリデーションに対応

過酢酸・過酸化水素・噴霧殺菌
一番厄介な芽胞菌まで死滅させる殺菌力

殺菌機器デモンストレーション
ホルムアルデヒドを取り扱う前に評価をお勧めします
安全キャビネット等クリーン機器のメンテナンス・導入・更新

クリーン機器性能検査
ご存知ですか?クリーン機器は定期的な性能検査が必要です

医療/製薬/研究用
クリーン機器の導入・更新
より使いやすく、快適な作業空間へ

クリーン機器資料編
クリーン機器に要求される基準などを網羅
防虫対策

防虫対策コンサルティング
より高い衛生環境の確保のために、効果的かつ具体的な防虫対策

クリーンルームの防虫対策
チャタテムシなどに代表される微細な昆虫の侵入を防止

防虫対策商品の有効な活用方法
防虫対策商品は、使用目的に応じた様々な種類と特性があります。

昆虫類の同定試験
昆虫類がどのような種類かを、その形態や遺伝子によって調べます。

防虫ネットの加工事例
外部からの侵入を物理的にカットする。
微生物関連対策
各種微生物受託試験
お客様のご要望に合わせた形式で試験を実施します。
-微生物・昆虫-1024x538.jpg)
同定検査(遺伝子解析)
微生物・昆虫
食品・医薬製造などの環境において発生した微生物の性質を同定
